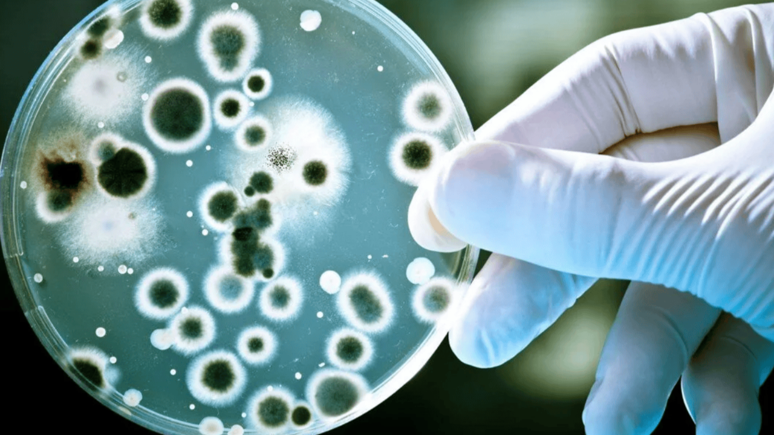
Evinizdeki bu eşya mikrop yuvası çıktı: Tuvaletten 40.000 kat daha pis!

TERMOS

Dünyaya termos satacaklar
Türkiye ve Çin’de üretim yapan iki firma olarak 25 milyon dolarlık bir yatırım yaptıklarını aktaran Termomug Yönetim Kurulu Başkanı Yılmaz, fabrikanın günde 40 bin adet üretim kapasitesi olacağını ve Şanlıurfa’yı önemli bir termos üretim merkezi haline getireceğini dile getirdi
Çelik
A101'e Orcamp kamp malzemeleri geliyor
A101 16 Mayıs 2024 aktüel ürünler kataloğu yayımlandı. A101’de bu Perşembe; Volta elektrikli motorlu bisikletten kamp malzemelerine, SEG buzdolabı ve çamaşır makinesinden tencere setlerine, piknik gereçlerinden bulgur, mercimek ve bebek bezi çeşitlerine kadar pek çok fırsat yer alıyor.
Kamp
A101 4 Nisan 2024 indirimli ürünler listesi
A101 4 Nisan 2024 indirimli ürünler listesi yayımlandı. 'Aldın aldın' kampanyası kapsamında geçerli termos, beyaz eşya ürünleri ve elektrikli bisiklet uygun fiyat ile satışa sunuluyor. İşte A101 4 Nisan 2024 indirimli ürünler listesinin ayrıntıları...
A101